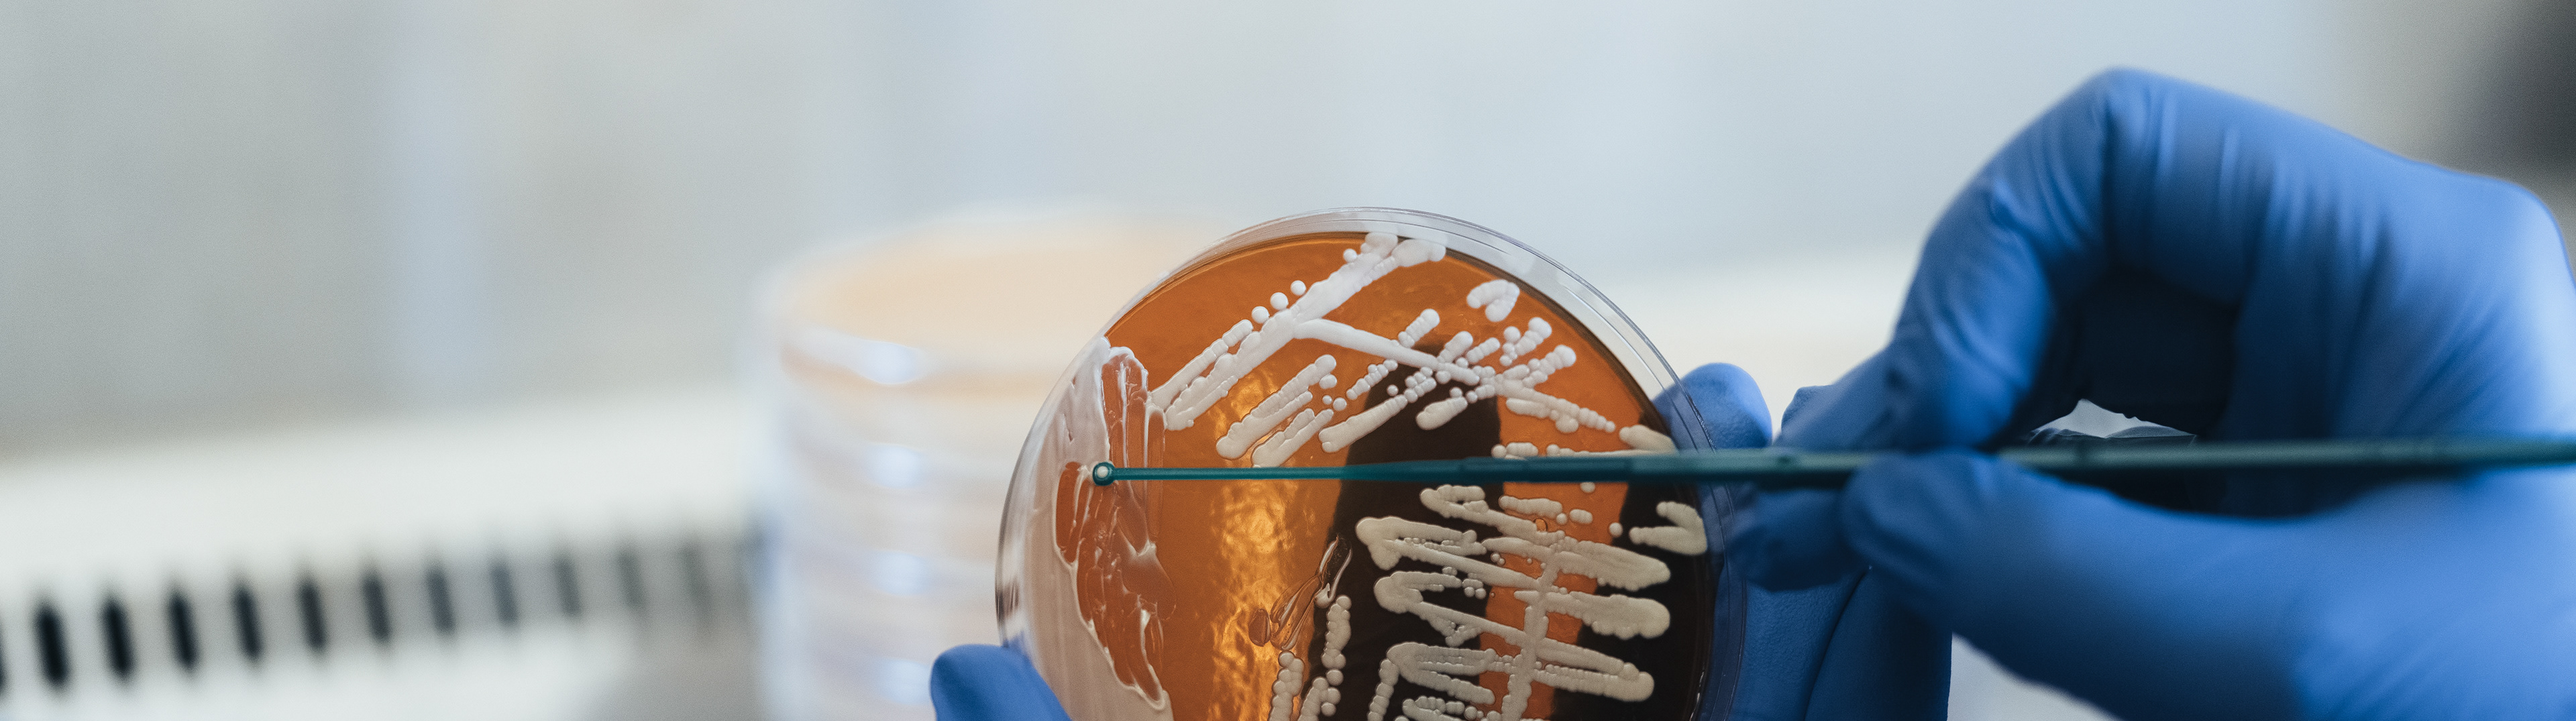

Heimplanet - MONO SERIES Minimal Pack

NORDA

HOSTPOINT

HEIMPLANET - Commuter Pack

TOYOTA

Cin Cin - Café
BIOSYNTH
